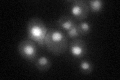
YNL201C
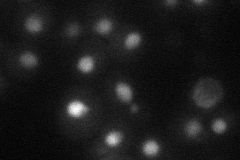
YNL201C
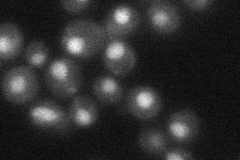
YNL201C
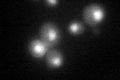
YNL201C

View description
Putative subunit of an evolutionarily conserved protein phosphatase complex containing the catalytic subunit Pph3p and the regulatory subunit Psy4p; required for cisplatin and oxaliplatin resistance; putative homolog of mammalian R3
Localization:
Intensity:
Fold change:
Significance:
-
C’ GFP library in SD
nucleus36.81 -
N' NOP1pr-GFP in SD

nucleus51.9989 -
N' TEF2pr-mCherry in SD
nucleus20.402 -
N' NATIVEpr-GFP in SD
nucleus38.3781 -
N' TEF2pr-VC and Cyto-VN in SD

below threshold24.7652 -
C’ GFP library in SD+DTT
nucleus34.390.93No -
C’ GFP library in SD+H2O2

nucleus34.470.93No -
C’ GFP library in Starvation Media

nucleus29.010.78No -
C’ GFP library on the background of Pup2-DaMP

nucleus -
C’ GFP library on the background of CCT mutant

nucleus34.14520.927496No
